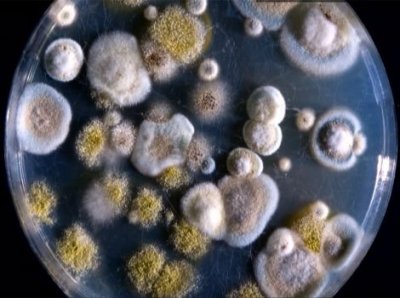
Пенициллин и цитрин - антибактериальные продукты плесени

Кряква распространена по всей Голарктике, за исключением тундры и лесотундры. На водоемах Южных Курильских островов кряква — обычная гнездящаяся и регулярно зимующая птица (ПСС, 1952).

В Тебердинском государственном заповеднике в течение нескольких лет ведутся исследования по выращиванию женьшеня. Эту работу возглавляет доктор биологических наук А. А. Малышев. Им выявлены особенности развития и роста женьшеня в горных условиях Теберды, проведен опыт введения его в лесную среду
Битва диванов | проверить объект на попадание в крт
Почта - posta2saita@mail.ru

Гималайский, или белогрудый медведь обитает в нашей стране только на юге Дальнего Востока. Типичный житель смешанных кедров-широколиственных лесов, он избегает тайги.

Сухонос и Гуменник / Птицы Южных Курил
Сухонос гнездится спорадически на территории Азии начиная от Южного Алтая на западе п кончая Сахалином на востоке и от долины р. Амура на севере до северо-восточных провинций Китая на юге. Он зимует на о-вах Хоккайдо и Хонсю (Hand-list..., 1958).

Тундровый лебедь и кликун / Птицы Южных Курил
Гнездовой ареал лебедя-кликуна — лесная зона Палеарктики. На Курильских островах лебеди-кликуны многочисленны на пролете весной и осенью (Yamashina, 1931; Гизенко, 1955).

Кенгуру — большее сумчатое животное
По широко распространенному мнению, кенгуру — удивительные животные Австралии — первым открыл мореплаватель британских островов Джеймс Кук. Но как оказалось за 140 лет до него, в 1629 г., голландский мореплаватель Франциск Пельсаэрт, познакомился с одним из видов кенгуру

Остров Ольхой — самый крупный из байкальских островов, расположен в средней части Байкала, у его западного берега. Длина его более 70 км, средняя ширина равна 10 км и площадь — около 730 км. квадратных.

Средняя белая цапля, Китайский волчок и Колпица / Птицы Южных Курил
Ареал средней белой цапли — Южная и Юго-Восточная Азия (Vaurie, 1965). Для Курильских островов —это редкая, возможно, гнездящаяся птица. Автором одна цапля отмечена на о. Кунашир утром 9 июля 1963 г. в пойме р. Тятина йедалеко от берега Тихого океана.

Серая и большая белая цапля / Птицы Южных Курил
Ареал серой цапли: Палеарктика — Европа, Азия, Северная Африка. На Курильских островах она отмечалась в небольшом количестве на весеннем и осеннем пролете (Гизенко, 1955). На о. Кунашир 19 августа 1962 г. одиночную серую цаплю наблюдал местный охотник П. Т. Милпчкин.

Большие змеи всегда вызывали у человека страх, мы ненавидим их и боимся буквально на генном уровне, этот страх не имеет рационального зерна и присущ людям с раннего детства.

Берингийский баклан / Птицы Южных Курил
Этот баклан населяет побережья Охотского и Берингова морей до Берингова пролива и несколько далее, а также тихоокеанский берег Северной Америки. Это обычная гнездящаяся птица всех Курильских островов (ПСС, 1951; Гизенко, 1955).

Краснолицый баклан / Птицы Южных Курил
Краснолицый баклан гнездится и живет оседло па Командорских, Алеутских и Курильских островах, а также на о. Мойирури (Mouyruri) близ Хоккайдо, где летом 1959 и 1960 гг. насчитывалось около 40 пар гнездящихся птиц (Fujimaki, 1961).

Японский баклан / Птицы Южных Курил
Японский баклан гнездится па скалистых морских берегах Южного Приморья, п-ова Корея, Северного Китая и Японии. На Курильских островах — это оседлая птица. В конце августа 1948 г.

Большой баклан / Птицы Южных Курил
Гнездовой ареал большого баклана — Палеарктика от Южной и частью Средней Европы на западе до Китая и Японии на востоке. О пребывании его на Курильских островах сведения противоречивы.

Северная качурка / Птицы Южных Курил
Распространена северная качурка на Курильских, Командорских, Алеутских островах, западном побережье Северной Америки, а также в северной части Атлантического океана.

В старинных наставлениях по красильному делу говорилось, что самая стойкая желтая краска для самых дорогих шелков добывается из «китайских желтых ягод». И доставляли эти «ягоды» караваны с далекого Востока в Европу вместе с шелками и заморскими пряностями.

Серая качурка / Птицы Южных Курил
Гнездовой ареал серой качурки охватывает Курильские, Ко-мандорские, Алеутские острова, часть восточного побережья Камчатки и берега Северной Америки. Она гнездится на Северных и Средних Курильских островах к югу до Симушира

Согласно Книге рекордов Гиннеса казуар – самая опасная птица на нашей планете. Это – самое крупное наземное существо, обитающее на Австралийском континенте и в Папуа Новой Гвинее.

Ареал тихоокеанского подвида глупыша занимает острова в Беринговом проливе, а также Курильские, Командорские и Алеутские острова и восточное побережье Камчатки. Зимой отмечался на Хоккайдо и Хонсю (Hand-list..., 1958).

Буллеров буревестник и Белолобый тайфунник / Птицы Южных Курил
В гнездовое время Буллеров буревестник встречается на мелких островах близ северной оконечности Новой Зеландии. Случайный залет птицы отмечен для о. Хонсю (Hand-list..., 1958).

Серый и пегий буревестник / Птицы Южных Курил
Гнездовой ареал серого буревестника расположен в южном полушарии и включает о. Тасмания, островки близ Новой Зеландии и юго-западного побережья Южной Америки (ПСС, 1951; Alexander, 1963).

Темноспинный альбатрос и Тонкоклювый буревестник / Птицы Южных Курил
Этот альбатрос гнездится на Гавайских островах. Вблизи Японских островов в прикурильских водах он встречается изредка в период кочевок (Hand-list..., 1958). О нахождении темпоспинного альбатроса в районе Курильских островов впервые сообщил М. М. Слепцов (1959).

Белоспинный и черноногий альбатрос / Птицы Южных Курил
Гнездование этой птицы доказано только на о-вах Идзу, Рюкю, Бонин и Уэйк (ПСС, 1951; Alexander, 1963). В водах Японских островов и Курильской гряды она встречается изредка на кочевках (Гизенко, 1955; Hand-list..., 1958; Слепцов, 1959).

Дальневосточная ядовитая медуза
Жителям Владивостока и его окрестностей давно известно, что в конце лета в прибрежных водах Амурского залива появляются маленькие медузы, называемые местным населением «крестовиками». В период купального сезона многие люди случайно прикасаются к этим на вид невинным прозрачным «грибам», мирно качающимся на волнах

Малая поганка / Птицы Южных Курил
Ареал этого подвида малой поганки распространяется на Восточный Китай, Индокитай и Японские острова. В пределах Советского Союза эта птица известна из Южного Приморья (Воробьев, 1954).

Жизнь так называемых божьих коровок
Часто мы проходим мимо самых обычных организмов, созданных природой, не подозревая, сколько неожиданного, интересного и даже удивительного скрывается за, казалось бы, таким знакомым и известным обликом. Божьи коровки — жуки семейства кокцинеллид,— вероятно

Попав в лес в начале сентября, даже мало внимательный человек заметит, что пеньки; прежде одиноко черневшие среди зелени деревьев, порой одеваются в наряд из желтовато-коричневых, упругих грибов.

Серощекая поганка / Птицы Южных Курил
Этот подвид серощекой поганки распространен в лесной и лесотундровой зоне Восточной Сибири, Дальнего Востока СССР и Северной Америки. На Южных Курильских островах поганка, по-видимому

Чернозобая гагара / Птицы Южных Курил
Ареал этвго подвида охватывает тундру и лесную зону Восточной Сибири и Дальнего Востока СССР. В водах Южных Курильских островов чернозобая гагара встречается в течение всего года, на пролетах, летних кочевках и зимовке

Персики с гладкой кожей - нектарин
Плоды персика бывают опушенные и голые — не опушенные. Голо-плодные персики получили название нектарин. Деревья, листья и плоды у нектарина обычно несколько мельче, чем у персиков опушенных, косточка отличается иным расположением бороздок, мякоть плода плотная, со своеобразным миндальным запахом и едва ощутимым горьковатым

Горностай (Mustela erminea) - представитель семейства куньих
Горностай (Mustela erminea) - это яркий представитель семейства куньих. Ареал обитания очень широк. В России, например, его можно встретить практически повсеместно. Имеет длинное, веретенообразное тело, треть которого приходится на хвост. Общая же длинна колеблется от 20 до 35 см.

Краснозобая гагара и Полярная гагара / Птицы Южных Курил
Краснозобая гагара распространена в зоне тундры, на севере лесной зоны Евразии и Северной Америки; гнездится на Северных Курильских островах — Парамушире и Шумшу (Yama- china, 1929; Подковыркин, 1955).

Эту пряную культуру использовали еще древние греки, для воскурения в храмах. Римляне настаивали на ней вино, дабы придать ему магические качества и ароматизировали воду для омовения рук.

Императорский пингвин – нелетающая птица
Самым крупным пингвином считается императорский. Его рост может достигать 120-130 см, правда, если пингвины сутулятся их рост, как правило, не превышает 90 см. Масса императорского пингвина колеблется от 20 до 45 кг.

На Крайнем Севере России у берегов Чукотки на острове Врангеля гнездятся белые гуси (Chen hyper-borea Pall.). За приверженность к тундровому ландшафту, за белую окраску оперения их называют нередко «снежными гусями».

Традиционный русский чай – напиток из ароматного и полезного кипрея (Иван - Чай)
Издавна на Руси употребляли чай, приготовленный из листьев и цветов кипрея, в народе он имеет и другие названия – Иван - Чай, дремуха, хрипняк, маточник, пушник. За пределами России, в Европе, растение Иван - Чай было также хорошо известен, здесь он назывался просто: «русский чай».

Известна группа бабочек, которые вместо того, чтобы питаться, «как положено», нектаром цветов, вьются около глаз различных животных, таких как олень, слон, лошадь, а иногда и возле человека и всасывают их глазные выделения.

Коала – животное Австралии из рода сумчатый медведь
Животное коала обитает в Австралии, этот сумчатый медведь единственный представитель одноименного семейства сумчатых. Сумчатый медведь – от. лат. Phascolarctos cinereus

Загадка белых шрамов на теле китов
Считается, что киты благодаря своим огромным размерам не имеют врагов. Единственный опасный для них хищник — касатка, да и та нападает в основном на раненых или обессиленных животных.

Рано утром 18 декабря 1969 г. жители поселка Нижнеянск Якутской области, расположенного более чем в 20 км от побережья моря, с удивлением обнаружили огромного моржа, мирно дремавшего вблизи котельной.

Большая белая акула - жизнь и обитание в подводном мире
Белая акула, которую также просто называют "большая белая" ("Great White"), является самым известным видом и крупнейшей хищной акулой на планете. Ее также называют "белой смертью", потому что она заслужила репутацию людоеда.

Одним осенним утром в Тувинских горах, ученым оно выдалось особенно тихим. Солнце скользнуло по изрезанным вершинам хребта Цаган-Шибету и залило светом остепененные склоны гор.

Лотос – сказочный букет на воде
Земноводное многолетнее растение. Корневище и ножка лотоса уходит, врастают довольно глубоко в подводный грунт. Лист лотоса имеет три разновидности: подводные (маленькие по виду чешуевидные), плавающие (по виду плоские, небольшие по размеру и держатся на тонких, гибких стеблях)

До 1963 г. в зоопарке «Аскания-Нова» степных орлов выращивали из еще неоперившихся орлят, взятых из естественных гнезд в целинной степи. Птиц содержали во все сезоны года в больших вольерах из крупной металлической сетки

Пауки и паутинная нить, настоящее чудо природы
Пауков многие считают страшными и вредными существами,но это не так. Например из 1000 видов пауков обитающих на равнинах Европы, опасен для человека только один - тарантул.
Пенициллин и цитрин - антибактериальные продукты плесени
Теперь имеется возможность сказать, что за последние 1—2 года полностью определилось значение пенициллина как могучего химико-терапевтического средства в борьбе с опасными микробами для человека.

Орловский рысак - золотой генофонд породы
Хорошая лошадь была основой крестьянского хозяйства в России. На ней выполняли все сельскохозяйственные работы, товарные перевозки. Лошади обеспечивали связь и транспорт в условиях бескрайних просторов и бездорожья нашей страны.

Дельфины – самые удивительные морские существа
Дельфины – не рыбы, а млекопитающие. Дельфины – теплокровные, и как у людей на свет у них появляется всего по одному детёнышу. Детёныши дельфинов рождаются длиной 90 – 130 сантиметров и вырастают приблизительно до 4 метров.

Растение маргаритка многолетняя семейства сложноцветных европейского происхождения с мочковатыми корнями, образует дернинки. Лопаточные листья в розетке прижаты к земле.

Манул (Felis manul) - дикая кошка
Внешний вид: самая маленькая из диких кошек нашей страны, примерно такого же размера (50 - 60 см), как домашняя кошка, ведет одинокий образ жизни, издает резкое фырканье или хриплое урчание.

прошлые века, как отмечали в своих записях путешественники, гималайские сурки встречались очень редко: можно было проехать по Тибету сотни километров и не встретить ни единого сурка.

Морские губки - красота подводного мира
Более миллиарда лет назад существовали только одноклеточные организмы очень простой структуры — протозоа. За время долгой эволюции некоторые из этих видов объединились, чтобы образовать более сложные организмы, состоящие из двух или более клеток.

Медузы – любопытные обитатели морей
Медузы принадлежат к типу стрекающих (Cnidaria) и классу сцифоидных (Scyphozoa). Слово Cnidaria в переводе с греческого означает «жалящая крапива», а Scyphozoa - «чаша».

Орлы - обязательный элемент степной экосистемы. В этих местах их можно встретить рядом с людьми. Орлов в наших степях три вида: степной орёл, орёл-могильник и беркут.

Раковинные узоры - Двустворчатые моллюски
включает в себя более 1О тысяч видов. Большинство из них живёт в морях, остальные - в пресноводных водоёмах: реках, озёрах, прудах. Места их обитания раковин различны: мягкий ил, заиленные пески, скальные и каменистые поверхности.

У этого растения много имен. Называют его, например, гигантским камышом — и не без оснований: стебли его достигают пяти, шестиметровой высоты. Называют тростником — итальянским, испанским, прованским — тоже неудивительно: на тростник оно и похоже, и состоит с ним в родстве — относится к тому же семейству злаков.

Галапагосская игуана — уникальная морская рептилия
Морская игуана (Amb-lYrhynchus cristatus) относится к одному из наиболее многочисленных и разнообразных семейств ящериц в Западном полушарии — игуани. С тех пор как Ч. Дарвин

Внимание биологов, изучающих процессы старения и естественной смерти, привлекают особенности этих явлений у осьминогов: у большинства изученных видов этих животных смерть самца наступает через 7—9 месяцев после достижения половой зрелости

Носуха (Коати) из семейства енотов
В Южной Америке живёт интересный и необычный зверёк с длинным предлинным носом, почти хоботом - таким же большим, как у известного всем проказника Буратино. Это носуха из емейства енотов.

Лекарственное растение - Лапчатка прямостоячая
В народе лапчатка прямостоячая известная как калган, дубровный корень, древлянка. Травянистое растение, высота которого до 40 см, корневище лапчатки прямостоячей короткое, цилиндрическое или клубневидное, многоглавое, внутри - красное снаружи - бурое с придаточными корнями.

Уникальная ботаническая находка
Лишь раз в году, в летнюю ночь на Ивана Купала, гласит народное предание, счастливцу дано отыскать цветущий папоротник. Легенда о чудо-цветке живет до сих пор, хотя со школьных лет всем известно, что папоротники не цветут, а размножаются спорами.

На востоке России находится один из самых таинственных уголков нашей планеты – уссурийский край. Здесь обитают очень редкие животные, например, амурский тигр и дальневосточный леопард, а с деревьев свешивается еще один, не менее интересный и редкий зверь – белогрудый медведь.

В истории биологии нередко случалось, что сущность изучаемых натуралистом организмов познавалась намного позже начала их интенсивного исследования. Так было и с лишайниками.

Уже полвека биологи говорят о сумчатом волке (Thylacinus cynocephalus) как об исчезнувшем виде: с 30-х годов достоверных данных о его существовании не было, а последний представитель этого вида умер в зоопарке г. Хобарта (Австралия) в 1936 г.

Винторогий козел, или мархур (Capra falconeri), как один из малочисленных видов копытных фауны нашей планеты внесен в «Красную Книгу». Состояние популяций на остальной части видового ареала (в Афганистане, Пакистане и Индии) также внушает большие опасения, поэтому этот вид внесен и в «Международную Красную Книгу».

Р. Г. Бюснель (Лаборатория акустической физиологии при Школе высших исследований, Париж) наблюдал «взаимодействие» между рыбаками из народности имрагенов, проживающих в Мавритании, и атлантическими дельфинами афалинами (Tursiops frunkatus).

Живые ископаемые у нас под ногами
Одним из аспектов проблемы конкретных путей и закономерностей эволюции — это исследование темпов эволюции разных таксонов (видов, родов, отрядов, классов и т. п.) животных и растений. Знание темпов эволюции организма и экологических особенностей биогеоценозов прошлого

О вирусах, вызывающих СПИД, известно уже довольно много. В частности, показано, что при заболевании поражается иммунная система, в результате чего погибают определенные, восприимчивые к вирусу клетки иммунной системы — хелперы.

Способность кашалотов нырять на километровые глубины в погоне за головоногими моллюсками и рыбой установлена уже давно по косвенным наблюдениям. Режимы погружения кашалотов, преследуемых судном, оказалось возможным проследить только с появлением на судах специализированных акустических станций.

Дневные бабочки — опылители красного клевера
Для культуры красного клевера — одной из лучших кормовых трав — остро стоит проблема опыления. Медоносные пчелы с их коротким хоботком «работают» недостаточно эффективно из-за глубокого залегания нектара.

В энтомофауне СССР лет 20 назад на Черноморском побережье Кавказа, в районе Сухуми, появился новый вид насекомого из отряда хоботных — японская цикадка (Recania japonica), внешне похожая на бабочку.

Кречетка, или степная пигалица (Chettusia gregaria), эндемик азиатских сухих степей и полупустынь — представитель отряда куликов семейства ржанковых (Charadr і idae).

Чумиза — злаковое однолетнее растение, из зерен которого может быть приготовлена хорошая крупа, не уступающая по своим качествам пшену. Одновременно чумиза является прекрасной кормовой культурой

История золотого напитка - кофе
Кофе - золото обыкновенного человека, и как золото это приносит каждому человеку [и женщина] чувство роскоши и благородства. Шейх Абд-Кэдир "В Похвале Кофе" 1857.

Разнообразие и подвиды грациозной кошки - тигр
Есть девять подвидов тигра, три из которых являются потухшими. Сегодня строго уменьшен их исторический диапазон в Бангладеш, Сибири, Иране, Афганистане, Индии, Китае, и Юго-Восточной Азии, включая три индонезийских острова.

Редис может быть разных видов и иметь разный окрас, он может быть не только черным и белым, но и красным, коричневым, лиловым, серым, розовым. Нарядным редисом хорошо украшать закуску, красиво уложив его на блюде.

Много лет назад на берегах наших лесных рек жили бобры. Эти крупные пушные звери-грызуны давно привлекли к себе внимание людей благодаря своим ценным шкуркам и мускусу.

В настоящее время можно считать прочно установленным, что жизнедеятельность внутренних органов и желез внутренней секреции контролируется высшим отделом центральной нервной системы — корой головного мозга.